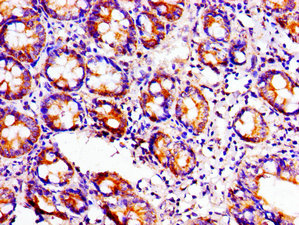

ACO1 Antibody
-
中文名稱:ACO1兔多克隆抗體
-
貨號:CSB-PA001161LA01HU
-
規格:¥440
-
圖片:
-
Western Blot
Positive WB detected in: HepG2 whole cell lysate, Hela whole cell lysate
All lanes: ACO1 antibody at 3µg/ml
Secondary
Goat polyclonal to rabbit IgG at 1/50000 dilution
Predicted band size: 99 kDa
Observed band size: 99 kDa -
Immunohistochemistry of paraffin-embedded human kidney tissue using CSB-PA001161LA01HU at dilution of 1:100
-
Immunohistochemistry of paraffin-embedded human small intestine tissue using CSB-PA001161LA01HU at dilution of 1:100
-
Immunofluorescent analysis of Hela cells using CSB-PA001161LA01HU at dilution of 1:100 and Alexa Fluor 488-congugated AffiniPure Goat Anti-Rabbit IgG(H+L)
-
-
其他:
產品詳情
-
產品描述:
CUSABIO uses a partial recombinant protein mapping within 508-745 amino acids of the human ACO1 protein to immunize the rabbit to produce the anti-ACO1 polyclonal antibody. This ACO1 antibody exists as the unconjugated IgG isoform. The purity of this antibody is 95%+ using protein G affinity chromatography. This ACO1 antibody shows reactivity in human samples. And it has been validated for use in ELISA, WB, IHC, and IF applications.
ACO1, also called aconitase, is an iron-sulfur cluster-containing enzyme essential for the tricarboxylic acid (TCA) cycle to generate energy through oxidative phosphorylation. ACO1 also has a role in regulating cellular iron homeostasis and has been implicated in other cellular processes, including RNA metabolism and DNA repair.
-
產品名稱:Rabbit anti-Homo sapiens (Human) ACO1 Polyclonal antibody
-
Uniprot No.:
-
基因名:ACO1
-
別名:ACO 1 antibody; ACO1 antibody; ACOC_HUMAN antibody; Aconitase 1 soluble antibody; Aconitase antibody; Aconitase1 antibody; Aconitate hydratase antibody; ACONS antibody; Citrate hydro lyase antibody; Citrate hydro-lyase antibody; Cytoplasmic aconitate hydratase antibody; Ferritin repressor protein antibody; IRE BP 1 antibody; IRE-BP 1 antibody; IREB 1 antibody; IREB1 antibody; IREBP antibody; IREBP1 antibody; Iron regulatory protein 1 antibody; Iron responsive element binding protein 1 antibody; Iron-responsive element-binding protein 1 antibody; IRP 1 antibody; IRP1 antibody; OTTHUMP00000045233 antibody
-
宿主:Rabbit
-
反應種屬:Human
-
免疫原:Recombinant Human Cytoplasmic aconitate hydratase protein (508-745AA)
-
免疫原種屬:Homo sapiens (Human)
-
標記方式:Non-conjugated
本頁面中的產品,ACO1 Antibody (CSB-PA001161LA01HU),的標記方式是Non-conjugated。對于ACO1 Antibody,我們還提供其他標記。見下表:
-
克隆類型:Polyclonal
-
抗體亞型:IgG
-
純化方式:>95%, Protein G purified
-
濃度:It differs from different batches. Please contact us to confirm it.
-
保存緩沖液:Preservative: 0.03% Proclin 300
Constituents: 50% Glycerol, 0.01M PBS, pH 7.4 -
產品提供形式:Liquid
-
應用范圍:ELISA, WB, IHC, IF
-
推薦稀釋比:
Application Recommended Dilution WB 1:500-1:5000 IHC 1:20-1:200 IF 1:50-1:200 -
Protocols:
-
儲存條件:Upon receipt, store at -20°C or -80°C. Avoid repeated freeze.
-
貨期:Basically, we can dispatch the products out in 1-3 working days after receiving your orders. Delivery time maybe differs from different purchasing way or location, please kindly consult your local distributors for specific delivery time.
-
用途:For Research Use Only. Not for use in diagnostic or therapeutic procedures.
相關產品
靶點詳情
-
功能:Bifunctional iron sensor that switches between 2 activities depending on iron availability. Iron deprivation, promotes its mRNA binding activity through which it regulates the expression of genes involved in iron uptake, sequestration and utilization. Binds to iron-responsive elements (IRES) in the untranslated region of target mRNAs preventing for instance the translation of ferritin and aminolevulinic acid synthase and stabilizing the transferrin receptor mRNA.; Conversely, when cellular iron levels are high, binds a 4Fe-4S cluster which precludes RNA binding activity and promotes the aconitase activity, the isomerization of citrate to isocitrate via cis-aconitate.
-
基因功能參考文獻:
- These results support the concept that IRP1 is an oxidative stress biosensor that mediates iron accumulation and cell death when deregulated by mitochondrial dysfunction. PMID: 28502703
- Results indicate that there is a dysregulation of DMT1 + IRE in IA testes, which might due to the up-regulation of IRP1 and HIF-1A. PMID: 28762519
- Evaluation of the iron regulatory protein-1 interactome has been presented. PMID: 29330752
- regulatory circuit involving FBXL5 and CIA acts through both IRPs to control iron metabolism and promote optimal cell growth PMID: 28768766
- Data suggest that Fe-S cluster of IRP1 plays role in sensing/regulating cellular iron homeostasis; IRP1 alternates between function as cytosolic aconitase [which contains Fe(4)-S(4) cluster in active-site cleft] and function as apoenzyme [which lacks Fe-S cluster] that binds to iron response element stem-loop structures present in several iron regulatory protein transcripts. [REVIEW] PMID: 28615439
- The SNP rs7874815 in the ACO1 gene was strongly associated with survival in pancreatic cancer. PMID: 26755275
- Our results confirm the observation that mitoNEET is important in transferring the iron sulfur clusters to the cytosolic aconitase in living cells and the His-87 ligand in mitoNEET plays important role in this process. PMID: 26778000
- Data show that IRP1 suppressed TfR1/DMT1 (+IRE) expression, limited the cellular iron content and decreased lactate dehydrogenase (LDH) release induced by hypoxia. PMID: 25727755
- These in vitro studies suggest that human GLRX3 is important for cytosolic Fe-S protein maturation. PMID: 26296460
- SIRT3 overexpression decreases TfR1 expression by inhibiting IRP1 and represses proliferation in pancreatic cancer cells. PMID: 24909164
- ACO1 gene expression was positively associated with adipogenic markers in subcutaneous and visceral adipose tissue. PMID: 25550467
- ACO1 genetic variation is associated with neuropathic pain and pain severity in HIV-infected patients on antiretroviral therapy PMID: 25144566
- MitoNEET governs a novel trafficking pathway to rebuild an Fe-S cluster into cytosolic aconitase/IRP1. PMID: 25012650
- Polymer-dependent translocation of IRP-1 in Cd(2+)-exposed cells may underlie effects of Cd(2+) on iron homeostasis. PMID: 25106854
- Data indicate that JTR-009, a benzimidazole, operated by preventing iron-regulatory protein-1 (IRP1) from binding to the iron-responsive element (IRE) in APP mRNA. PMID: 23935819
- Aco1 encodes a moonlighting protein that has aconitase activity as well as mRNA binding ability. PMID: 8041788
- Data indicate that silencing of Grx3 in HeLa cells decreases the activities of several cytosolic Fe/S proteins, including iron-regulatory protein 1, a major component of posttranscriptional iron regulation. PMID: 23615448
- Studies indicate that several genes have been linked to iron homeostasis, including transferrin (TF), iron regulatory protein 1 (ACO1) and transferrin receptor 2 (TFR2). PMID: 23817740
- Lead specifically induces dysregulation of IRP1 protein by activating the ERK1/2 signaling pathway indicating a novel role for IRP1 and the ERK/MAPK pathway in vascular endothelial functions. PMID: 22502979
- The RNA-binding and aconitase forms of IRP-1 can undergo interconversion dependent on the density of cells growing in culture. PMID: 22544036
- Ggenetic polymorphisms of the iron regulatory protein 1 and 2 genes may be associated with development of age-related macular degeneration. PMID: 22331484
- Molecular genetic analysis revealed point mutations within the FTL IRE. PMID: 22020773
- Dual-luciferase reporter assay showed that iron regulatory protein 1 (IRP)1 was directly downregulated by hypoxia-inducible factor 1/hypoxia response element system. PMID: 21360641
- Single nucleotide polymorphism in ACO1 gene is associated with cutaneous malignant melanoma. PMID: 20574843
- Selective translational control of the Alzheimer amyloid precursor protein transcript by iron regulatory protein-1. PMID: 20558735
- ATP/ADP binding maintains IRP-1 in a non-IRE-binding state. PMID: 20569198
- iron regulatory protein-1-mediated inhibition of hypoxia-inducible factor-2a translation is linked to the anti-inflammatory 15-deoxy-delta12,14-prostaglandin J2 PMID: 20354189
- gene coding and flanking regions were sequenced and examined for mutations that might modulate the iron burden of individuals harboring the common mutant hemochromatosis HFE genotype or cause hemochromatosis independent of mutations in the HFE gene PMID: 11783942
- Structural changes associated with switching activities of human iron regulatory protein 1 PMID: 11812787
- liver levels or this protein are down-regulated in hemochromatosis PMID: 12196178
- functional in the activation of iron uptake PMID: 12572667
- data suggest that the differential regulation of IRP1 and IRP2 during hypoxia may be important for cellular adaptation to low oxygen tension. PMID: 12855587
- A phosphomimetic mutation at Ser-138 renders IRP1 sensitive to iron-dependent degradation. PMID: 12972614
- Toxoplasma gondii infection resulted in increased activity in the iron response protein IRP1, which, in this state, stabilizes transferrin receptor mRNA from degradation. PMID: 15349772
- iron-replete HepG2 cells exhibit a narrow range of maximal responsiveness of the IRP-regulatory mechanism PMID: 15543932
- Apo-IRP1 exists as an equilibrium mixture of monomers and dimers in solution; however, only monomeric IRP1 is observed in complex with the iron regulatory element (IRE). PMID: 15938636
- Comparison of IRP1 in its aconitase form with known structures of homologous enzymes reveals well-conserved folds and active site environments with significantly different surface shapes and charge distributions. PMID: 16407072
- IRP1 controls iron homeostasis during cell proliferation, inflammation, and in response to diseases altering cytosolic Fe-S cluster assembly or disassembly. PMID: 16424901
- IRP1 activity level is higher in monocytes and macrophages of hereditary hemochrosis (HH) patients than in those of control subjects, and is increased in the duodenal samples of the patients with HH and iron-deficiency anemia. PMID: 16503547
- Overexpression of iron regulatory protein 1 suppresses growth of tumor xenografts PMID: 17127713
- Results describe thet effect of hypoxia on the binding and subcellular distribution of iron regulatory proteins 1 and 2. PMID: 17200797
- Thus, proper folding of human iron regulatory protein 1 strongly depends on its cellular environment, in contrast to other members of the aconitase family. PMID: 17244191
- Although the iron-responsive element does not itself hydrolyze ATP, its presence enhances iron regulatory protein-1's ATPase activity, and ATP hydrolysis results in loss of the complex in gel shift assays. PMID: 17521334
- analysis of the iron regulatory protein system PMID: 17604281
- Hypertransfusional (>8 transfusions/year) iron in liver biopsies correlated with increased expression (RNA) for iron regulatory proteins 1 and 2 (3-, 9- to 11-fold) and hepcidin RNA: (5- to 8-fold), while ferritin H and L RNA remained constant. PMID: 17613866
- Expression of TfR1 mRNA is increased when maternal iron deficiency progressed while there is no change in the expression of IRP1 mRNA in the placenta. PMID: 17877204
- Downregulated by HBX in human hepatoma cell lines. PMID: 18262302
- This study shows that expression of the transferrin receptor (TfR) is downregulated, whereas expression of the ferritin heavy chain is upregulated in Chlamydia trachomatis infected HeLa-229 cells. PMID: 19688112
顯示更多
收起更多
-
亞細胞定位:Cytoplasm, cytosol.
-
蛋白家族:Aconitase/IPM isomerase family
-
數據庫鏈接:
Most popular with customers
-
YWHAB Recombinant Monoclonal Antibody
Applications: ELISA, WB, IHC, IF, FC
Species Reactivity: Human, Mouse, Rat
-
-
-
-
-
-
-